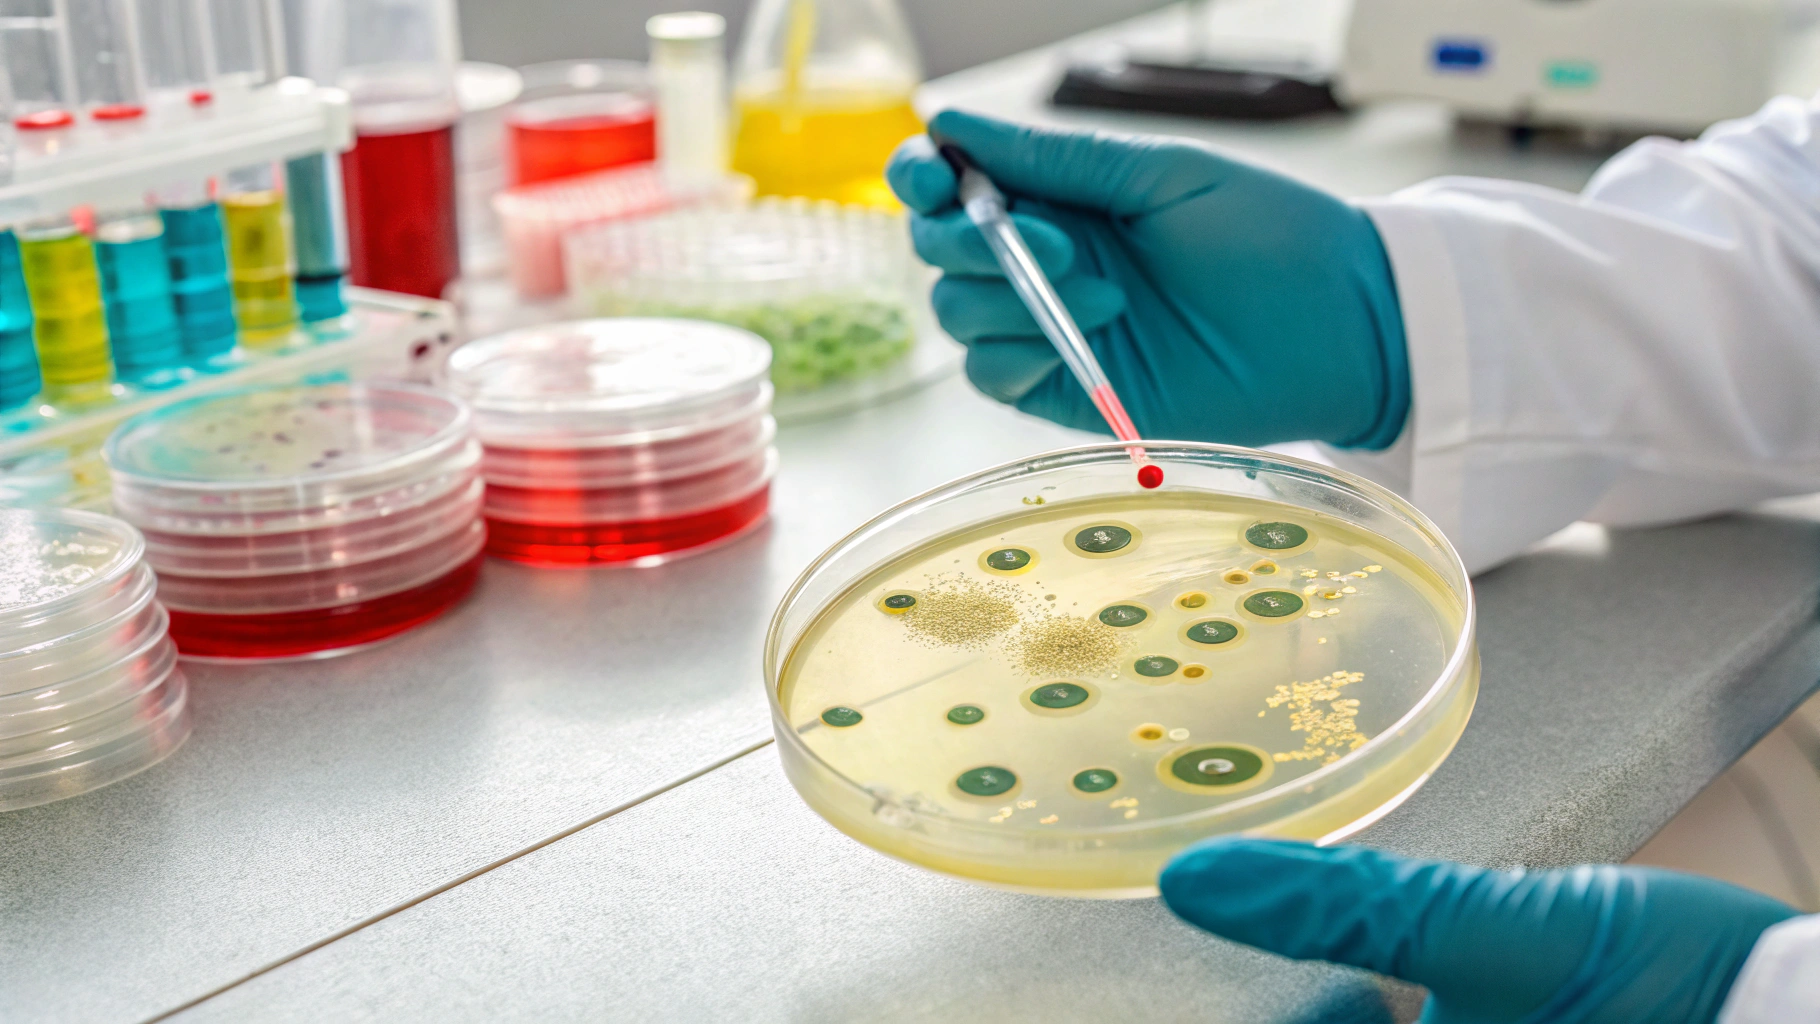

티스토리 뷰
목차
반응형

비뇨기과는 남성과 여성 모두에게 중요한 신장, 요관, 방광, 요도, 전립선 등의 문제를 진료하는 전문과입니다. 아래는 주요 진료 항목별 치료 내용, 평균 비용, 건강보험 적용 여부를 설명해보도록 하겠습니다.
1. 주요 진료 항목 비교표
| 진료 항목 | 치료/검사 내용 | 평균 비용 (비급여 기준) | 건강보험 적용 여부 |
|---|---|---|---|
| 요도염 | 소변검사, 세균 배양, 항생제 처방 | 30,000 ~ 60,000원 | 대부분 적용 |
| 전립선염 | 전립선 초음파, 소변검사, 약물치료 | 60,000 ~ 120,000원 | 일부 항목 적용 |
| 요로결석 | CT 또는 X-ray 검사, 체외충격파 쇄석술(ESWL) | ESWL 기준 20만 ~ 40만원 | 검사 및 치료 모두 적용 |
| 조루/발기부전 | 면담, 호르몬 검사, 약물 처방 | 초진·검사 50,000원~ / 약값 별도 | 비보험 (자비 부담) |
| 야뇨증 | 소변검사, 약물치료, 생활습관 개선 | 30,000 ~ 80,000원 | 부분 적용 |
| 포경수술 | 국소마취 후 포피 제거 | 15세 이하 5~10만원 / 성인 30~60만원 | 15세 이하만 적용 |
| 정관수술 | 국소마취, 정관 절제 및 봉합 | 25만원 ~ 50만원 | 비보험 |
| 전립선암 검사 | PSA 혈액검사, 직장수지검사 | 30,000 ~ 70,000원 | 고위험군은 적용 |
2. 보험 적용 관련 유의사항
- 건강보험이 적용되는 항목이라도 일부 초음파·약제 등은 비급여로 분류될 수 있음
- 성기능 관련 진료(발기부전, 조루 등)는 대부분 비보험
- 정관수술, 성인 포경수술 등은 미용 목적 판단 시 비급여
- 의사의 진단에 따라 건강보험 적용 여부가 달라질 수 있으므로, 병원 내 안내 필수 확인
3. 건강보험 적용을 받으려면?
의사의 진단 하에 '치료 목적'으로 판단되면 건강보험이 적용됩니다. 단순 검사 목적이 아닌 증상이나 질환이 동반된 경우에는 보험 혜택을 받을 가능성이 높습니다.
FAQ
Q1. 비뇨기과 진료 시 건강보험증이 꼭 필요한가요?
A1. 건강보험 적용을 받기 위해서는 본인 확인을 위한 신분증(모바일 신분증 포함)을 지참해야 합니다.
Q2. 진료 시 창피하지 않을까요?
A2. 남녀 구분 진료가 가능한 병원도 있으며, 대부분 의사와 1:1 진료실 내 상담으로 프라이버시가 보장됩니다.
Q3. 실비 보험 청구는 가능한가요?
A3. 비뇨기계 질환 중 검사·수술·약 처방 등 치료 목적이라면 실손보험 청구 가능성이 높습니다. 단, 미용·기능개선 목적은 제외됩니다.
Q4. 남성만 진료받는 곳인가요?
A4. 아닙니다. 방광염, 요실금, 요로감염 등 여성도 비뇨기과 진료가 필요할 수 있습니다. 최근엔 여성 비뇨기과 전문의도 증가하고 있습니다.

반응형
'건강지식' 카테고리의 다른 글
| 영양제 궁합 : 함께 복용 시 찰떡궁합 조합과 상극 조합 (0) | 2025.05.06 |
|---|---|
| 영양제 언제 먹는게 좋을까? 비타민 보충제 효과적인 섭취 시간 (0) | 2025.05.05 |
| 50대 60대가 꼭 챙겨야 할 건강식품 및 건강보조제 영양제 (0) | 2025.05.05 |
| 오메가3 메가도스 요법의 긍정적인 효과 섭취 방법 (1) | 2025.05.05 |
| 뇌 건강을 위협하는 일상 속 습관 5가지 (0) | 2025.04.30 |